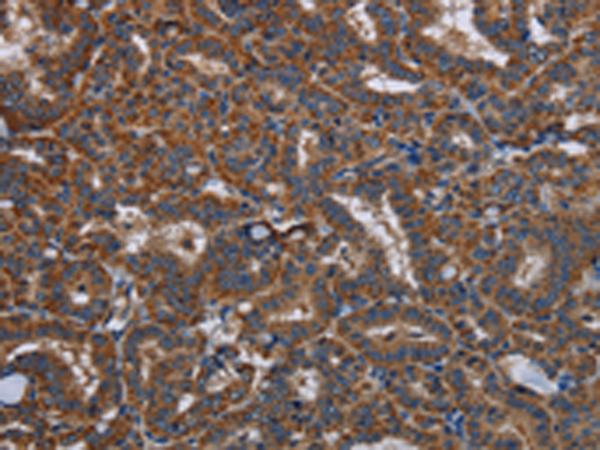

克隆類型: rabbit polyclonal
|
Background: |
This gene encodes a tyrosine protein kinase, which maybe involved in the regulation of mast cell degranulation, and erythroid differentiation. Alternatively spliced transcript variants encoding different isoforms have been found for this gene. |
|
Applications: |
ELISA, IHC |
|
Name of antibody: |
LYN |
|
Immunogen: |
Fusion protein of human LYN |
|
Full name: |
v-yes-1 Yamaguchi sarcoma viral related oncogene homolog |
|
Synonyms: |
JTK8; p53Lyn; p56Lyn |
|
SwissProt: |
P07948 |
|
ELISA Recommended dilution: |
1000-2000 |
|
IHC positive control: |
Human thyroid cancer and Human liver cancer |
|
IHC Recommend dilution: |
25-100 |
購物車
幫助
021-54845833/15800441009
